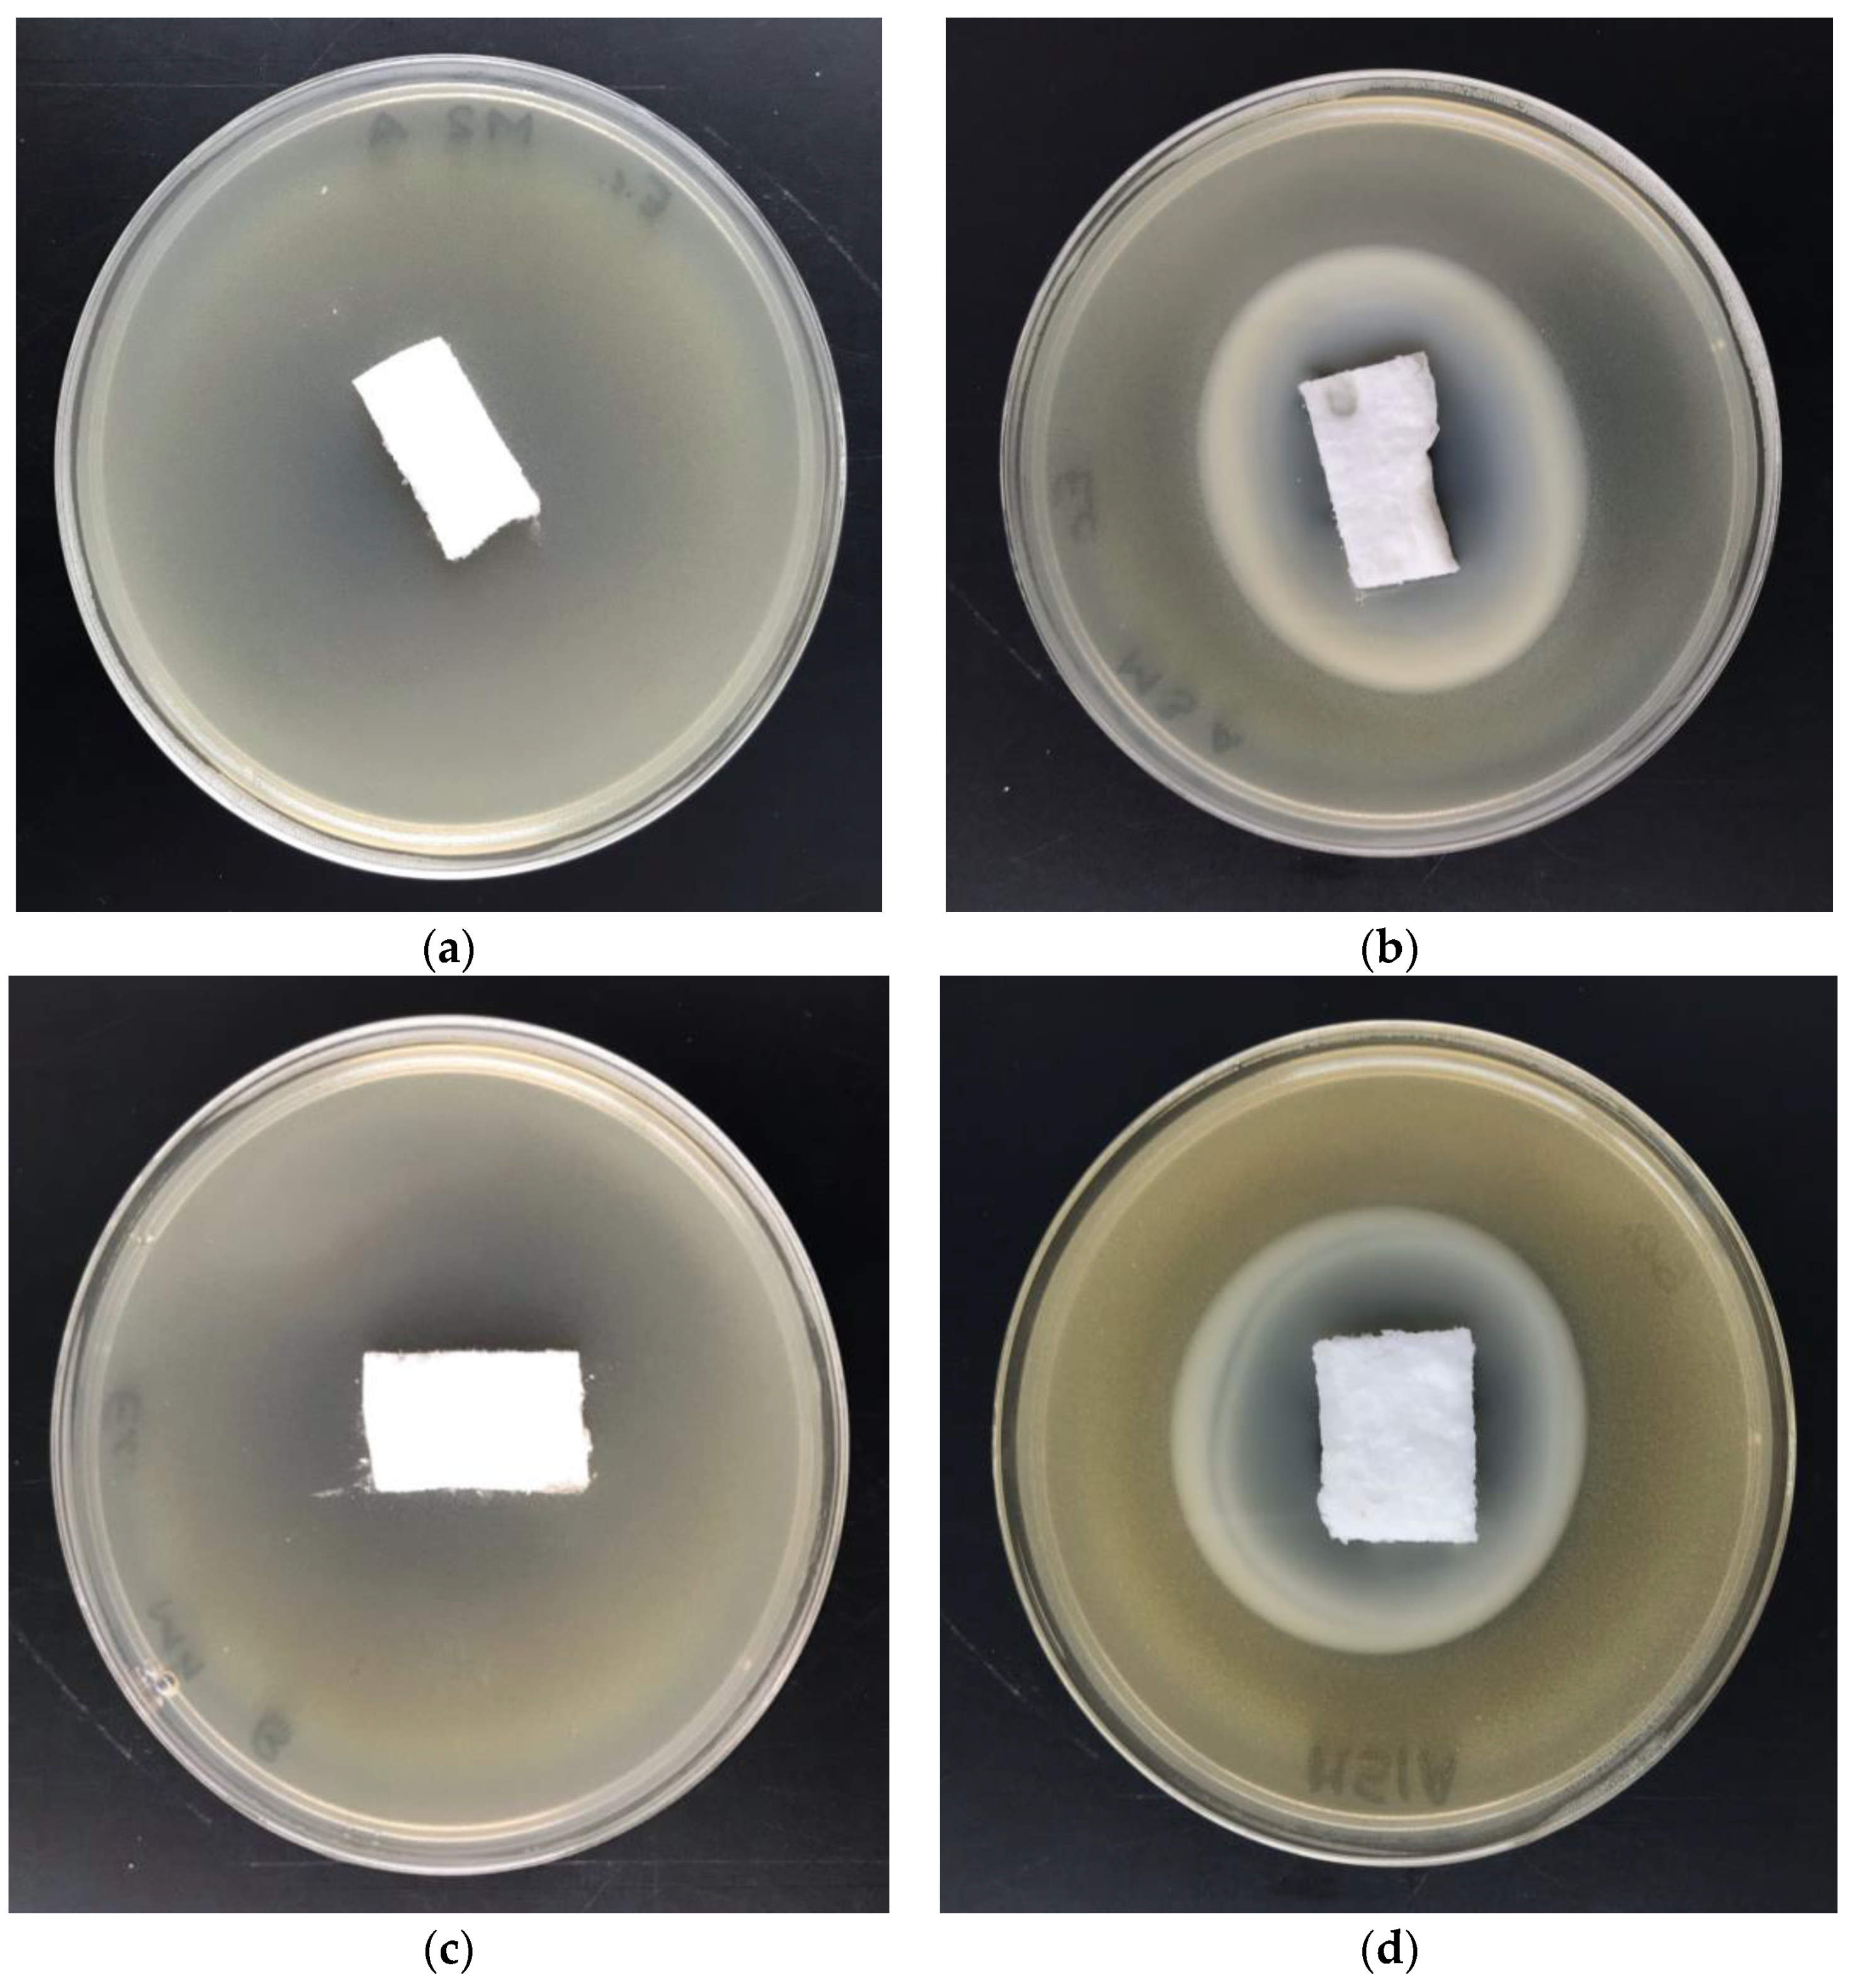
Antibiotics 10 01327 g012

Poly(lactic acid)/Zinc/Alginate Complex Material: Preparation and Antimicrobial Properties
Abstract
:1. Introduction
2. Materials and Methods
2.1. Materials
- Alginic acid sodium salt, C5H7O4COONa (CAS: 9005-38-3) were purchased from Millipore Sigma (St. Louis, MO, USA);
- Bacterial strains: Escherchia coli (ATCC 25922) and Staphylococcus aureus (ATCC 6538) were purchased from Microbiologics (St. Cloud, MN, USA);
- Fungal strains: Aspergillus niger van Tieghem (ATCC 6275) and Chaetomium globosum (ATCC 6205) were purchased from Microbiologics.
- Poly(lactic acid) was provided by NatureWorks LLC (Minnetonka, MN, USA), type Ingeo™ 3251D, with an MFR value of 30–40 g/10 min (at 190 °C/2.16 kg);
- Zinc (II) chloride, ZnCl2, 98% (CAS: 7646-85-7) was purchased from Millipore Sigma.
2.2. Methods
2.2.1. Preparation of Fibrous Material—Melt-Blown Process
2.2.2. Modification—Dip-Coting
2.2.3. Morphological and Structural Characterization—Scanning Electron Microscopy
2.2.4. Morphological and Structural Characterization—Specific Surface Area
2.2.5. Morphological and Structural Characterization—Contact Angle and Wettability
2.2.6. Chemical Characterization—Atomic Absorption Spectrometry with Flame Excitation
2.2.7. Antimicrobial Activity
3. Results and Discussion
3.1. Scanning Electron Microscopy
3.2. Specific Surface Area
3.3. Contact Angle and Wettability
3.4. Flame Atomic Absorption Spectrometry
3.5. Antimicrobial Activity—Disc-Diffusion Assay
4. Conclusions
Author Contributions
Funding
Acknowledgments
Conflicts of Interest
References
- Nethi, S.K.; Das, S.; Patra, C.R.; Mukherjee, S. Recent advances in inorganic nanomaterials for wound-healing applications. Biomater. Sci. 2019, 7, 2652–2674. [Google Scholar] [CrossRef] [PubMed]
- Jones, V.; Grey, J.G.; Harding, K.G. Wound dressings. BMJ 2006, 332, 707–780. [Google Scholar] [CrossRef] [PubMed]
- Dhivya, S.; Padma, V.V.; Santhini, E. Wound dressings—A review. BioMedicine 2015, 5, 24–28. [Google Scholar] [CrossRef] [PubMed]
- Ghomi, E.R.; Khalili, S.; Khorasani, S.N.; Neisiany, R.E.; Ramakrishna, S. Wound dressings: Current advances and future directions. J. Appl. Polym. Sci. 2019, 136, 47738. [Google Scholar] [CrossRef] [Green Version]
- Pandey, A.K.; Dwivedi, A.K. Recent advancement in wound healing dressing material. Int. J. Pharm. Sci. Res. 2019, 10, 2572–2577. [Google Scholar] [CrossRef]
- Garlotta, D. A literature review of poly(lactic acid). J. Polym. Environ. 2001, 9, 63–84. [Google Scholar] [CrossRef]
- Auras, R.; Lim, L.T.; Selke, S.E.M.; Tsuji, H. Poly(lactic acid): Synthesis, Structures, Properties, Processing, and Applications; John Wiley & Sons, Inc.: Hoboken, NJ, USA, 2010. [Google Scholar] [CrossRef]
- Lasprilla, A.J.R.; Martinez, G.A.R.; Lunelli, B.H.; Jardini, A.L.; Filho, R.M. Poly-lactic acid synthesis for application in biomedical devices—A review. Biotechnol. Adv. 2012, 30, 321–328. [Google Scholar] [CrossRef]
- Zhou, J.; Han, S.; Dou, Y.; Lu, J.; Wang, C.; He, H.; Li, X.; Zhang, J. Nanostructured poly(l-lactide) matrix as novel platform for drug delivery. Int. J. Pharm. 2013, 448, 175–188. [Google Scholar] [CrossRef] [PubMed]
- Farah, S.; Anderson, D.G.; Langer, R. Physical and mechanical properties of PLA, and their functions in widespread applications—A comprehensive review. Adv. Drug. Deliv. Rev. 2016, 107, 367–392. [Google Scholar] [CrossRef] [Green Version]
- Koh, J.J.; Zhang, X.; He, C. Fully biodegradable Poly(lactic acid)/Starch blends: A review of toughening strategies. Int. J. Biol. Macromol. 2018, 109, 99–113. [Google Scholar] [CrossRef] [PubMed]
- Nofar, M.; Sacligil, D.; Carreau, P.J.; Kamal, M.R.; Heuzey, M.C. Poly (lactic acid) blends: Processing, properties and applications. Int. J. Biol. Macromol. 2019, 125, 307–360. [Google Scholar] [CrossRef]
- Sharif, A.; Mondal, S.; Hoque, M.E. Polylactic acid (PLA)-based nanocomposites: Processing and properties. In Bio-Based Polymers and Nanocomposites: Preparation, Processing, Properties & Performance; Springer Nature: Cham, Switzerland, 2019; pp. 233–254. [Google Scholar]
- Alam, F.; Shukla, V.R.; Varadarajan, K.M.; Kumar, S. Microarchitected 3D printed polylactic acid (PLA) nanocomposite scaffolds for biomedical applications. J. Mech. Behav. Biomed. Mater. 2020, 103, 103576. [Google Scholar] [CrossRef] [PubMed]
- Kliem, S.; Kreutzbruck, M.; Bonten, C. Review on the biological degradation of polymers in various environments. Materials 2020, 13, 4586. [Google Scholar] [CrossRef] [PubMed]
- Wang, C.-Y.; Makvandi, P.; Zare, E.N.; Tay, F.R.; Niu, L.-N. Advances in antimicrobial organic and inorganic nanocompounds in biomedicine. Adv. Ther. 2020, 3, 2000024. [Google Scholar] [CrossRef]
- Saidin, S.; Jumat, M.A.; Mohd Amin, N.A.A.; Saleh Al-Hammadi, A.S. Organic and inorganic antibacterial approaches in combating bacterial infection for biomedical application. Mater. Sci. Eng. C 2021, 118, 111382. [Google Scholar] [CrossRef] [PubMed]
- Mahltig, B.; Soltmann, U.; Haase, H. Modification of algae with zinc, copper and silver ions for usage as natural composite for antibacterial applications. Mater. Sci. Eng. C 2013, 33, 979–983. [Google Scholar] [CrossRef] [PubMed]
- Kwiczak-Yigitbasi, J.; Lacin, O.; Demir, M.; Ahan, R.E.; Seker, U.O.S.; Baytekin, B. A sustainable preparation of catalytically active and antibacterial cellulose metal nanocomposites: Via ball milling of cellulose. Green Chem. 2020, 22, 455–464. [Google Scholar] [CrossRef]
- Pettinari, C.; Pettinari, R.; Di Nicola, C.; Tombesi, A.; Scuri, S.; Marchetti, F. Antimicrobial MOFs. Coord. Chem. Rev. 2021, 446, 214121. [Google Scholar] [CrossRef]
- Song, J.M. Silver as antibacterial agent: Metal nanoparticles to nanometallopharmaceuticals (Silver based antibacterial nanometallopharmaceuticals). In Proceedings of the 2010 IEEE International Conference on Nano/Molecular Medicine and Engineering, Hung Hom, China, 5–9 December 2010; pp. 98–101. [Google Scholar]
- Cheng, Y.-J.; Zeiger, D.N.; Howarter, J.A.; Zhang, X.; Lin, N.J.; Antonucci, J.M.; Lin-Gibson, S. In situ formation of silver nanoparticles in photocrosslinking polymers. J. Biomed. Mater. Res. Part B Appl. Biomater. 2011, 97 B, 124–131. [Google Scholar] [CrossRef]
- Jin, G.; Prabhakaran, M.P.; Nadappuram, B.P.; Sing, G.; Kai, D.; Ramakrishna, S. Electrospun poly(L-lactic acid)-co-poly(ε-caprolactone) nanofibres containing silver nanoparticles for skin-tissue engineering. J. Biomater. Sci. Polym. Ed. 2012, 23, 2337–2352. [Google Scholar] [CrossRef]
- Xie, C.; Lu, X.; Wang, K. Pulse electrochemical synthesis of spherical hydroxyapatite and silver nanoparticles mediated by the polymerization of polypyrrole on metallic implants for biomedical applications. Part. Part. Syst. Charact. 2015, 32, 630–635. [Google Scholar] [CrossRef]
- Wan, C.; Li, J. Cellulose aerogels functionalized with polypyrrole and silver nanoparticles: In-situ synthesis, characterization and antibacterial activity. Carbohydr. Polym. 2016, 146, 362–367. [Google Scholar] [CrossRef] [PubMed]
- Shuai, C.; Xu, Y.; Feng, P.; Wang, G.; Xiong, S.; Peng, S. Antibacterial polymer scaffold based on mesoporous bioactive glass loaded with in situ grown silver. Chem. Eng. J. 2019, 374, 304–315. [Google Scholar] [CrossRef]
- Calamak, S.; Aksoy, E.A.; Ertas, N.; Erdogdu, C.; Sagiroglu, M.; Ulubayram, K. Ag/silk fibroin nanofibers: Effect of fibroin morphology on Ag+ release and antibacterial activity. Eur. Polym. J. 2015, 67, 99–112. [Google Scholar] [CrossRef]
- Duan, C.; Meng, J.; Wang, X.; Meng, X.; Sun, X.; Xu, Y.; Zhao, W.; Ni, Y. Synthesis of novel cellulose- based antibacterial composites of Ag nanoparticles@ metal-organic frameworks@ carboxymethylated fibers. Carbohydr. Polym. 2018, 193, 82–88. [Google Scholar] [CrossRef] [PubMed]
- Xie, C.M.; Lu, X.; Wang, K.F.; Meng, F.Z.; Jiang, O.; Zhang, H.P.; Zhi, W.; Fang, L.M. Silver nanoparticles and growth factors incorporated hydroxyapatite coatings on metallic implant surfaces for enhancement of osteoinductivity and antibacterial properties. ACS Appl. Mater. Interfaces 2014, 6, 8580–8589. [Google Scholar] [CrossRef] [PubMed]
- Dubnika, A.; Loca, D.; Rudovica, V.; Parekh, M.B.; Berzina-Cimdina, L. Functionalized silver doped hydroxyapatite scaffolds for controlled simultaneous silver ion and drug delivery. Ceram. Int. 2017, 43, 3698–3705. [Google Scholar] [CrossRef]
- Li, J.; Kang, L.; Wang, B.; Chen, K.; Tian, X.; Ge, Z.; Zeng, J.; Xu, J.; Gao, W. Controlled release and long-term antibacterial activity of dialdehyde nanofibrillated cellulose/silver nanoparticle composites. ACS Sustain. Chem. Eng. 2019, 7, 1146–1158. [Google Scholar] [CrossRef]
- Jia, Z.; Lv, X.; Hou, Y.; Wang, K.; Ren, F.; Xu, D.; Wang, Q.; Fan, K.; Xie, C.; Lu, X. Mussel-inspired nanozyme catalyzed conductive and self-setting hydrogel for adhesive and antibacterial bioelectronics. Bioact. Mater. 2021, 6, 2676–2687. [Google Scholar] [CrossRef] [PubMed]
- Vaidhyanathan, B.; Vincent, P.; Vadivel, S.; Karuppiah, P.; Abdullah, N.; Deep, A.D.; Sadhasivam, R.; Vimalraj, S.; Saravanan, S. Fabrication and investigation of the suitability of chitosan-silver composite scaffolds for bone tissue engineering applications. Process Biochem. 2021, 100, 178–187. [Google Scholar] [CrossRef]
- Bagchi, B.; Kar, S.; Dey, S.K.; Bhandary, S.; Roy, D.; Mukhopadhyay, T.; Das, S.; Nandy, P. In situ synthesis and antibacterial activity of copper nanoparticle loaded natural montmorillonite clay based on contact inhibition and ion release. Colloids Surf. B Biointerfaces 2013, 108, 358–365. [Google Scholar] [CrossRef] [PubMed]
- Ilnicka, A.; Walczyk, M.; Lukaszewicz, J.P.; Janczak, K.; Malinowski, R. Antimicrobial carbon materials incorporating copper nano-crystallites and their PLA composites. J. Appl. Polym. Sci. 2016, 133, 43429. [Google Scholar] [CrossRef]
- García, A.; Rodríguez, B.; Giraldo, H.; Quintero, Y.; Quezada, R.; Hassan, N.; Estay, H. Copper-modified polymeric membranes for water treatment: A comprehensive review. Membranes 2021, 11, 93. [Google Scholar] [CrossRef] [PubMed]
- Aničić, N.; Kurtjak, M.; Jeverica, S.; Suvorov, D.; Vukomanović, M. Antimicrobial polymeric composites with embedded nanotextured magnesium oxide. Polymers 2021, 13, 2183. [Google Scholar] [CrossRef] [PubMed]
- Scopus Base: 6905 Document Results on Antibacterial Zinc. Available online: https://www-1scopus-1com-100001411012f.han.p.lodz.pl/results/results.uri?sid=94895d0abb0adeb79616d9f4561396f8&src=s&sot=b&sdt=b&origin=searchbasic&rr=&sl=34&s=TITLE-ABS-KEY(Antibacterial%20%20Zinc)&searchterm1=Antibacterial%20%20Zinc&searchTerms=&connectors=&field1=TITLE_ABS_KEY&fields=) (accessed on 11 September 2021).
- Vallee, B.L.; Falchuk, K.H. The biochemical basis of zinc physiology. Physiol. Rev. 1993, 73, 79–118. [Google Scholar] [CrossRef] [PubMed]
- Fosmire, G.J. Zinc toxicity. Am. J. Clin. Nutr. 1990, 51, 225–227. [Google Scholar] [CrossRef] [PubMed]
- Cheknev, S.B.; Vostrova, E.I.; Apresova, M.A.; Piskovskaya, L.S.; Vostrov, A.V. Deceleration of bacterial growth in Staphylococcus aureus and Pseudomonas aeruginosa cultures in the presence of copper and zinc cations. Zhurnal Mikrobiol. Epidemiol. Immunobiol. 2015, 2, 9–17. [Google Scholar] [PubMed]
- Jones, N.; Ray, B.; Ranjit, K.T.; Manna, A.C. Antibacterial activity of ZnO nanoparticle suspensions on a broad spectrum of microorganisms. FEMS Microbiol. Lett. 2008, 279, 71–76. [Google Scholar] [CrossRef] [Green Version]
- Hoseinnejad, M.; Jafari, S.M.; Katouzian, I. Inorganic and metal nanoparticles and their antimicrobial activity in food packaging applications. Crit. Rev. Microbiol. 2018, 44, 161–181. [Google Scholar] [CrossRef] [PubMed]
- Yuvasravana, R.; George, P.P.; Devanna, N.; Apsana, G. Fabrication and comparison between anti-bacterial properties of metal oxide nanoparticles prepared by a biogenic approach. J. Bionanosci. 2018, 12, 408–416. [Google Scholar] [CrossRef]
- Li, Y.; Liao, C.; Tjong, S.C. Recent advances in zinc oxide nanostructures with antimicrobial activities. Int. J. Mol. Sci. 2020, 21, 8836. [Google Scholar] [CrossRef] [PubMed]
- Geetha, P. Antibacterial and anticancer activities of biogenic synthesized Ag and ZnO NPS. Int. J. Innov. Technol. Expl. Eng. 2019, 8, 3143–3147. [Google Scholar]
- Hu, H.; Yu, L.; Qian, X.; Chen, Y.; Chen, B.; Li, Y. Chemoreactive nanotherapeutics by metal peroxide based nanomedicine. Adv. Sci. 2021, 8, 2000494. [Google Scholar] [CrossRef]
- Bock, C.W.; Katz, A.K.; Glusker, J.P. Hydration of zinc ions: A comparison with magnesium and beryllium ions. J. Amer. Chem. Soc. 1995, 117, 3754–3765. [Google Scholar] [CrossRef]
- Xia, J.; Shi, Y.; Zhang, Y.; Miao, Q.; Tang, W. Deprotonation of zinc(II)−water and zinc(II)−alcohol and nucleophilicity of the resultant zinc(II) hydroxide and zinc(II) alkoxide in double-functionalized complexes: Theoretical studies on models for hydrolytic zinc enzymes. Inorg. Chem. 2003, 42, 70–77. [Google Scholar] [CrossRef]
- Maret, W. Zinc and human disease. Met. Ions Life Sci. 2013, 13, 389–414. [Google Scholar] [CrossRef]
- Krezel, A.; Maret, W. The biological inorganic chemistry of zinc ions. Arch. Biochem. Biophys. 2016, 611, 3–19. [Google Scholar] [CrossRef] [PubMed] [Green Version]
- Ogawa, Y.; Kawamura, T.; Shimadaet, S. Zinc and skin biology. Arch. Biochem. Biophys. 2016, 611, 113–119. [Google Scholar] [CrossRef] [PubMed]
- Abendrot, M.; Chęcińska, L.; Kusz, J.; Lisowska, K.; Zawadzka, K.; Felczak, A.; Kalinowska-Lis, U. Zinc(II) complexes with amino acids for potential use in dermatology: Synthesis, crystal structures, and antibacterial activity. Molecules 2020, 25, 951. [Google Scholar] [CrossRef] [PubMed] [Green Version]
- Pellei, M.; Del Bello, F.; Porchia, M.; Santini, C. Zinc coordination complexes as anticancer agents. Coord. Chem. Rev. 2021, 445, 214088. [Google Scholar] [CrossRef]
- Dudev, T.; Lim, C. Tetrahedral vs. octahedral zinc complexes with ligands of biological interest: A DFT/CDM study. J. Am. Chem. Soc. 2000, 122, 11146–11153. [Google Scholar] [CrossRef]
- Durrant, P.J.; Durrant, B. Introduction to Advanced Inorganic Chemistry; Longman, Green &Co Ltd.: London, UK, 1962; pp. 508–522. ISBN 0582442133. [Google Scholar]
- Sthoer, A.; Hladılkova, J.; Lund, M.; Tyrode, E. Molecular insight into carboxylic acid–alkali metal cations interactions: Reversed affinities and ion-pair formation revealed by non-linear optics and simulations. Phys. Chem. Chem. Phys. 2019, 21, 11329–11344. [Google Scholar] [CrossRef] [PubMed] [Green Version]
- Draget, K.L.; Taylor, C. Chemical, physical and biological properties of alginates and their biomedical implications. Food Hydrocoll. 2011, 25, 251–256. [Google Scholar] [CrossRef]
- Lee, K.Y.; Mooney, D.J. Alginate: Properties and biomedical applications. Prog. Polym. Sci. 2012, 37, 106–126. [Google Scholar] [CrossRef] [PubMed] [Green Version]
- Pawar, S.N.; Edgar, K.J. Alginate derivatization: A review of chemistry, properties and applications. Biomaterials 2012, 33, 3279–3305. [Google Scholar] [CrossRef]
- Fernando, I.P.S.; Kim, D.; Nah, J.W.; Jeon, Y.J. Advances in functionalizing fucoidans and alginates (bio)polymers by structural modifications: A review. Chem. Eng. J. 2019, 355, 33–48. [Google Scholar] [CrossRef]
- Zhang, C.; Show, P.-L.; Ho, S.-H. Progress and perspective on algal plastics—A critical review. Bioresour. Technol. 2019, 289, 121700. [Google Scholar] [CrossRef] [PubMed]
- Kuznetsova, T.A.; Andryukov, B.G.; Besednova, N.N.; Zaporozhets, T.S.; Kalinin, A.V. Marine algae polysaccharides as basis for wound dressings, drug delivery, and tissue engineering: A review. J. Mar. Sci. Eng. 2020, 8, 481. [Google Scholar] [CrossRef]
- Scopus Base: 5294 Documents Results on Alginates for Drug Delivery. Available online: https://www-1scopus-1com-10000145y03aa.han.p.lodz.pl/results/results.uri?sid=4ed83aab7077f9b156f7eba71e34db0d&src=s&sot=b&sdt=b&origin=searchbasic&rr=&sl=41&s=TITLE-ABS-KEY(alginate%20for%20drug%20delivery)&searchterm1=alginate%20for%20drug%20delivery&searchTerms=&connectors=&field1=TITLE_ABS_KEY&fields= (accessed on 1 September 2021).
- Gholamali, I.; Yadollahi, M. Bio-nanocomposite polymer hydrogels containing nanoparticles for drug delivery: A Review. Regen. Eng. Transl. Med. 2021, 7, 129–146. [Google Scholar] [CrossRef]
- Jana, P.; Shyam, M.; Singh, S.; Jayaprakash, V.; Dev, A. Biodegradable polymers in drug delivery and oral vaccination. Eur. Polym. J. 2021, 142, 110155. [Google Scholar] [CrossRef]
- Salamanna, F.; Gambardella, A.; Contartese, D.; Visani, A.; Fini, M. Nano-based biomaterials as drug delivery systems against osteoporosis: A systematic review of preclinical and clinical evidence. Nanomaterials 2021, 11, 530. [Google Scholar] [CrossRef] [PubMed]
- Li, M.; Sun, Y.; Ma, C.; Hua, Y.; Zhang, L.; Shen, J. Design and investigation of penetrating mechanism of octaarginine-modified alginate nanoparticles for improving intestinal insulin delivery. J. Pharm. Sci. 2021, 110, 268–279. [Google Scholar] [CrossRef]
- Volpatti, L.R.; Facklam, A.L.; Cortinas, A.B.; Lu, Y.C.; Matranga, M.A.; MacIsaac, C.; Hill, M.C.; Langer, R.; Anderson, D.G. Microgel encapsulated nanoparticles for glucose-responsive insulin delivery. Biomaterials 2021, 267, 120458. [Google Scholar] [CrossRef] [PubMed]
- Bulut, E. Development and optimization of Fe3+-crosslinked sodium alginate-methylcellulose semi-interpenetrating polymer network beads for controlled release of ibuprofen. Int. J. Biol. Macromol. 2021, 168, 823–883. [Google Scholar] [CrossRef] [PubMed]
- Freitas, E.D.; Freitas, V.M.S.; Rosa, P.C.P.; da Silva, M.G.C.; Vieira, M.G.A. Development and evaluation of naproxen-loaded sericin/alginate beads for delayed and extended drug release using different covalent crosslinking agents. Mater. Sci. Eng. C 2021, 118, 111412. [Google Scholar] [CrossRef] [PubMed]
- Santinon, C.; Dantas de Freitas, E.; Gurgel Carlos da Silva, M.; Gurgel Adeodato Vieira, M. Modification of valsartan drug release by incorporation into sericin/alginate blend using experimental design methodology. Eur. Polym. J. 2021, 153, 110506. [Google Scholar] [CrossRef]
- Jing, C.; Li, B.; Tan, H.; Zhang, C.; Liang, H.; Na, H.; Chen, S.; Liu, C.; Zhao, L. Alendronate-decorated nanoparticles as bone-targeted alendronate carriers for potential osteoporosis treatment. ACS Appl. Bio Mater. 2021, 4, 4907–4916. [Google Scholar] [CrossRef]
- Lakkakula, J.R.; Gujarathi, P.; Pansare, P.; Tripathi, S. A comprehensive review on alginate-based delivery systems for the delivery of chemotherapeutic agent: Doxorubicin. Carbohydr. Polym. 2021, 259, 117696. [Google Scholar] [CrossRef] [PubMed]
- Mallakpour, S.; Azadi, E.; Hussain, C.M. Chitosan, alginate, hyaluronic acid, gums, and β-glucan as potent adjuvants and vaccine delivery systems for viral threats including SARS-CoV-2: A review. Int. J. Biol. Macromol. 2021, 182, 1931–1940. [Google Scholar] [CrossRef] [PubMed]
- Song, M.; Xia, W.; Tao, Z.; Zhu, B.; Zhang, W.; Liu, C.; Chen, S. Self-assembled polymeric nanocarrier-mediated co-delivery of metformin and doxorubicin for melanoma therapy. Drug Deliv. 2021, 28, 594–606. [Google Scholar] [CrossRef]
- Sreekanth Reddy, O.; Subha, M.C.S.; Jithendra, T.; Madhavi, C.; Chowdoji Rao, K. Curcumin encapsulated dual cross linked sodium alginate/montmorillonite polymeric composite beads for controlled drug delivery. J. Pharm. Anal. 2021, 11, 191–199. [Google Scholar] [CrossRef] [PubMed]
- Sun, H.; Zhang, C.; Zhang, B.; Song, P.; Xu, X.; Gui, X.; Chen, X.; Lu, G.; Li, X.; Liang, J.; et al. 3D printed calcium phosphate scaffolds with controlled release of osteogenic drugs for bone regeneration. Chem. Eng. J. 2022, 427, 130961. [Google Scholar] [CrossRef]
- Scopus Base: 3749 Document Results on Alginates in Tissue Engineering. Available online: https://www-1scopus-1com-10000145y0303.han.p.lodz.pl/results/results.uri?sid=dbef89d705f695750247b64d1f980f7b&src=s&sot=b&sdt=b&origin=searchbasic&rr=&sl=46&s=TITLE-ABS-KEY(alginate%20for%20tissue%20engineering)&searchterm1=alginate%20for%20tissue%20engineering&searchTerms=&connectors=&field1=TITLE_ABS_KEY&fields= (accessed on 1 September 2021).
- Sahoo, D.R.; Biswal, T. Alginate and its application to tissue engineering. SN Appl. Sci. 2021, 3, 30. [Google Scholar] [CrossRef]
- Kohli, N.; Sharma, V.; Orera, A.; Sawadkar, P.; Owji, N.; Frost, O.G.; Bailey, R.J.; Snow, M.; Knowles, J.C.; Blunn, G.W.; et al. Pro-angiogenic and osteogenic composite scaffolds of fibrin, alginate and calcium phosphate for bone tissue engineering. J. Tissue Eng. 2021, 12, 20417314211005610. [Google Scholar] [CrossRef] [PubMed]
- Sathain, A.; Monvisade, P.; Siriphannon, P. Bioactive alginate/carrageenan/calcium silicate porous scaffolds for bone tissue engineering. Mater. Today Commun. 2021, 26, 102165. [Google Scholar] [CrossRef]
- Naranda, J.; Bračič, M.; Vogrin, M.; Maver, U. Recent advancements in 3d printing of polysaccharide hydrogels in cartilage tissue engineering. Materials 2021, 14, 3977. [Google Scholar] [CrossRef] [PubMed]
- Pushp, P.; Gupta, M.K. Cardiac tissue engineering: A role for natural biomaterials. In Bioactive Natural Products for Pharmaceutical Applications; Advanced Structured Materials; Pal, D., Nayak, A.K., Eds.; Springer: Cham, Switzerland, 2021; Volume 140. [Google Scholar] [CrossRef]
- Boulais, L.; Jellali, R.; Pereira, U.; Leclerc, E.; Bencherif, S.A.; Legallais, C. Cryogel-integrated biochip for liver tissue engineering. ACS Appl. Bio Mater. 2021, 4, 5617–5626. [Google Scholar] [CrossRef]
- Shulimzon, T.R.; Giladi, S.; Zilberman, M. Catheter injectable hydrogel-based scaffolds for tissue engineering applications in lung disease. Isr. Med. Assoc. J. 2021, 22, 736–740. [Google Scholar] [PubMed]
- Campiglio, C.E.; Carcano, A.; Draghi, L. RGD-pectin microfiber patches for guiding muscle tissue regeneration. J. Biomed. Mater. Res. Part A 2021, in press. [Google Scholar] [CrossRef] [PubMed]
- Ghaderinejad, P.; Najmoddin, N.; Bagher, Z.; Saeed, M.; Karimi, S.; Simorgh, S.; Pezeshki-Modaress, M. An injectable anisotropic alginate hydrogel containing oriented fibers for nerve tissue engineering. Chem. Eng. J. 2021, 420, 130465. [Google Scholar] [CrossRef]
- Barros, N.R.; Kim, H.-J.; Gouidie, M.J.; Lee, K.J.; Bandaru, P.; Banton, E.A.; Sarikhani, E.; Sun, W.; Zhang, S.; Cho, H.J.; et al. Biofabrication of endothelial cell, dermal fibroblast, and multilayered keratinocyte layers for skin tissue engineering. Biofabrication 2021, 13, 035030. [Google Scholar] [CrossRef] [PubMed]
- Scopus Base: 1392 Document Results on Alginates in Tissue Engineering. Available online: https://www-1scopus-1com-10000145y0316.han.p.lodz.pl/results/results.uri?sid=33b3b9f2600cb7bbc5975c67d12053da&src=s&sot=b&sdt=b&origin=searchbasic&rr=&sl=43&s=TITLE-ABS-KEY(alginate%20for%20wound%20dressings)&searchterm1=alginate%20for%20wound%20dressings&searchTerms=&connectors=&field1=TITLE_ABS_KEY&fields= (accessed on 1 September 2021).
- Arora, S.; Nagpal, M.; Kaur, M. Recent updates on biopolymers based wound dressings. Asian J. Chem. 2021, 33, 1457–1470. [Google Scholar] [CrossRef]
- Azhar, F.F.; Rostamzadeh, P.; Khordadmehr, M.; Mesgari-Abbasi, M. Evaluation of a novel bioactive wound dressing: An in vitro and in vivo study. J. Wound Care 2021, 30, 482–490. [Google Scholar] [CrossRef] [PubMed]
- Jing, X.; Sun, Y.; Ma, X.; Hu, H. Marine polysaccharides: Green and recyclable resources as wound dressings. Mater. Chem. Front. 2021, 5, 5595–5616. [Google Scholar] [CrossRef]
- Garcia, T.F.; Silva, P.G.A.; Barcelos, B.J.; Miranda, M.G.R.; Alonso, C.S.; Abreu, M.N.S.; Borges, E.L. Criteria to evaluate the quality of alginate wound dressings. Rev. Bras. Enferm. 2021, 74, e20201091. [Google Scholar] [CrossRef] [PubMed]
- De Luca, I.; Pedram, P.; Moeini, A.; Cerruti, P.; Peluso, G.; Di Salle, A.; Germann, N. Nanotechnology development for formulating essential oils in wound dressing materials to promote the wound-healing process: A review. Appl. Sci. 2021, 11, 1713. [Google Scholar] [CrossRef]
- Kibungu, C.; Kondiah, P.P.D.; Kumar, P.; Choonara, Y.E. This review recent advances in chitosan and alginate-based hydrogels for wound healing application. Front. Mater. 2021, 8, 681960. [Google Scholar] [CrossRef]
- Weng, L.; Zhang, X.; Fan, W.; Lu, Y. Development of the inorganic nanoparticles reinforced alginate-based hybrid fiber for wound care and healing. J. Appl. Polym. Sci. 2021, 138, 51228. [Google Scholar] [CrossRef]
- Shen, H.Y.; Liu, Z.-H.; Hong, J.-S.; Wu, M.S.; Shiue, S.-J.; Lin, H.-Y. Controlled-release of free bacteriophage nanoparticles from 3D-plotted hydrogel fibrous structure as potential antibacterial wound dressing. J. Control. Release 2021, 331, 154–163. [Google Scholar] [CrossRef] [PubMed]
- Li, J.; He, J.; Huang, Y. Role of alginate in antibacterial finishing of textiles. Int. J. Biol. Macromol. 2017, 94, 466–473. [Google Scholar] [CrossRef] [PubMed]
- Caterson, E.J.; Nesti, L.J.; Li, W.-J.; Danielson, K.G.; Albert, T.J.; Vaccaro, A.R.; Tuan, R.S. Three-dimensional cartilage formation by bone marrow-derived cells seeded in polylactide/alginate amalgam. J. Biomed. Mater. Res. 2001, 57, 394–403. [Google Scholar] [CrossRef]
- Caterson, E.J.; Li, W.J.; Nesti, L.J.; Albert, T.; Danielson, K.; Tuan, R.S. Polymer/alginate amalgam for cartilage-tissue engineering. Ann. N. Y. Acad. Sci. 2002, 961, 134–138. [Google Scholar] [CrossRef] [PubMed]
- Wayne, J.S.; McDowell, C.L.; Shields, K.J.; Tuan, R.S. In vivo response of polylactic acid-alginate scaffolds and bone marrow-derived cells for cartilage tissue engineering. Tissue Eng. 2005, 11, 953–963. [Google Scholar] [CrossRef] [PubMed]
- Kessler, M.; Esser, E.; Groll, J.; Tessmar, J. Bilateral PLA/alginate membranes for the prevention of postsurgical adhesions. J. Biomed. Mater. Res. Part B Appl. Biomater. 2016, 104, 1563–1570. [Google Scholar] [CrossRef] [PubMed]
- Wu, H.; Liu, J.; Fang, Q.; Xiao, B.; Wan, Y. Establishment of nerve growth factor gradients on aligned chitosan-polylactide /alginate fibers for neural tissue engineering applications. Colloids Surf. B Biointerfaces 2017, 160, 598–609. [Google Scholar] [CrossRef] [PubMed]
- Yang, M.; Yang, T.; Jia, J.; Lu, T.; Wang, H.; Yan, X.; Wang, L.; Yu, L.; Zhao, Y. Fabrication and characterization of DDAB/PLA-alginate composite microcapsules as single-shot vaccine. RSC Adv. 2018, 8, 13612–13624. [Google Scholar] [CrossRef] [Green Version]
- Pandey, G.; Chaudhari, R.; Joshi, B.; Choudhary, S.; Kaur, J.; Joshi, A. Fluorescent biocompatible platinum-porphyrin–doped polymeric hybrid particles for oxygen and glucose biosensing. Sci. Rep. 2019, 9, 5029. [Google Scholar] [CrossRef] [PubMed]
- Li, X.; Saeed, S.S.; Beni, M.H.; Morovvati, M.R.; Angili, S.N.; Toghraie, D.; Khan, A. Experimental measurement and simulation of mechanical strength and biological behavior of porous bony scaffold coated with alginate-hydroxyapatite for femoral applications. Comp. Sci. Technol. 2021, 214, 108973. [Google Scholar] [CrossRef]
- Yokoyama, F.; Achife, C.E.; Takahira, K.; Yamashita, Y.; Monobe, K.; Kusano, F.; Nishi, K. Morphologies of oriented alginate gels crosslinked with various divalent metal ions. J. Macromol. Sci. Part B 1992, 31, 463–483. [Google Scholar] [CrossRef]
- Pistone, S.; Qoragllu, D.; Smistad, G.; Hiorth, M. Formulation and preparation of stable cross-linked alginate-zinc nanoparticles in the presence of a monovalent salt. Soft Matter 2015, 11, 5765–5774. [Google Scholar] [CrossRef] [PubMed] [Green Version]
- Pérez-Madrigal, M.M.; Torras, J.; Casanovas, J.; Haring, M.; Alemán, C.; Díaz, D.D. Paradigm shift for preparing versatile M2+-free gels from unmodified sodium alginate. Biomacromolecules 2017, 18, 2967–2979. [Google Scholar] [CrossRef]
- Frígols, B.; Martí, M.; Salesa, B.; Hernández-Oliver, C.; Aarstad, O.; Teialeret Ulset, A.-S.; Sӕtrom, G.I.; Aachmann, F.L.; Serrano-Aroca, A. Graphene oxide in zinc alginate films: Antibacterial activity, cytotoxicity, zinc release, water sorption/diffusion, wettability and opacity. PLoS ONE 2019, 14, e0212819. [Google Scholar] [CrossRef] [PubMed] [Green Version]
- Scopus Base: 792 Document Results on Zinc Alginate. Available online: https://www-1scopus-1com-100001411053a.han.p.lodz.pl/results/results.uri?sid=0c7262af62088e8c85153ce6d35be38c&src=s&sot=b&sdt=b&origin=searchbasic&rr=&sl=28&s=TITLE-ABS-KEY(zinc%20alginate)&searchterm1=zinc%20alginate&searchTerms=&connectors=&field1=TITLE_ABS_KEY&fields= (accessed on 1 September 2021).
- Jang, L.K.; Nguyen, D.; Geesey, G.G. An equilibrium model for absorption of multiple divalent metals by alginate gel under acidic conditions. Water Res. 1999, 33, 2826–2832. [Google Scholar] [CrossRef]
- Chan, L.W.; Jin, Y.; Heng, P.W.S. Cross-linking mechanisms of calcium and zinc in production of alginate microspheres. Int. J. Pharm. 2002, 242, 255–258. [Google Scholar] [CrossRef]
- Lai, Y.L.; Annadurai, G.; Huang, F.C.; Lee, J.F. Biosorption of Zn(II) on the different Ca-alginate beads from aqueous solution. Bioresour. Technol. 2008, 99, 6480–6487. [Google Scholar] [CrossRef]
- Lai, Y.L.; Thirumavalavan, M.; Lee, J.F. Effective adsorption of heavy metal ions (Cu2+, Pb2+, Zn2+) from aqueous solution by immobilization of adsorbents on Ca-alginate beads. Toxicol. Environ. Chem. 2010, 92, 697–705. [Google Scholar] [CrossRef]
- Plazinski, W.; Drach, M. Binding of bivalent metal cations by α-l-guluronate: Insights from the DFT-MD simulations. New J. Chem. 2015, 39, 3987–3994. [Google Scholar] [CrossRef]
- Zhou, Q.; Kang, H.; Bielec, M.; Wu, X.; Cheng, Q.; Wei, W.; Dai, H. Influence of different divalent ions cross-linking sodium alginate-polyacrylamide hydrogels on antibacterial properties and wound healing. Carbohydr. Polym. 2018, 197, 292–304. [Google Scholar] [CrossRef]
- Iskandar, L.; Rojo, L.; Di Silvio, L.; Deb, S. The effect of chelation of sodium alginate with osteogenic ions, calcium, zinc, and strontium. J. Biomater. Appl. 2019, 34, 573–584. [Google Scholar] [CrossRef] [PubMed]
- Cardoso, S.L.; Costa, C.S.D.; Da Silva, M.G.C.; Vieira, M.G.A. Insight into zinc(II) biosorption on alginate extraction residue: Kinetics, isotherm and thermodynamics. J. Environ. Chem. Eng. 2020, 8, 103629. [Google Scholar] [CrossRef]
- Lucaci, A.R.; Bulgariu, D.; Ahmad, I.; Bulgariu, L. Equilibrium and kinetics studies of metal ions biosorption on alginate extracted from marine red algae biomass (Callithamnion corymbosum sp.). Polymers 2020, 12, 1888. [Google Scholar] [CrossRef] [PubMed]
- Cendon, F.V.; Salomão, B.B.; Jorge, R.M.M.; Mathias, A.L. Mechanical and optical evaluation of alginate hydrospheres produced with different cross-linking salts for industrial application. Colloid Polym. Sci. 2021, 299, 693–703. [Google Scholar] [CrossRef]
- Hu, C.; Lu, W.; Mata, A.; Nishinari, K.; Fang, Y. Ions-induced gelation of alginate: Mechanisms and applications. Int. J. Biol. Macromol. 2021, 177, 578–588. [Google Scholar] [CrossRef]
- Sutirman, Z.A.; Sanagi, M.M.; Wan Aini, W.I. Alginate-based adsorbents for removal of metal ions and radionuclides from aqueous solutions: A review. Int. J. Bio. Macromol. 2021, 174, 216–228. [Google Scholar] [CrossRef]
- Kudzin, M.H.; Mrozińska, Z.; Walawska, A.; Sójka-Ledakowicz, J. Biofunctionalization of textile materials. 1. Biofunctionalization of poly(propylene) (PP) nonwovens fabrics by Alafosfalin. Coatings 2019, 9, 412. [Google Scholar] [CrossRef] [Green Version]
- Kudzin, M.H.; Mrozińska, Z. Biofunctionalization of textile materials. 2. Antimicrobial modification of poly(lactide) (PLA) nonwoven fabrics by fosfomycin. Polymers 2020, 12, 768. [Google Scholar] [CrossRef] [PubMed] [Green Version]
- Kudzin, M.H.; Mrozińska, Z. Biofunctionalization of textile materials.3. Biofunctionalization of poly(lactide) (PLA) nonwovens fabrics by KI. Coatings 2020, 10, 593. [Google Scholar] [CrossRef]
- Sójka-Ledakowicz, J.; Kudzin, M.H. Effect of plasma modification on the chemical structure of a polyethylene terephthalate fabrics surface. Fibres Text. East. Eur. 2014, 22, 118–122. [Google Scholar]
- Kudzin, M.H.; Mrozinska, Z.; Kaczmarek, A.; Lisiak-Kucinska, A. Deposition of copper on poly(lactide) non-woven fabrics by magnetron sputtering–fabrication of new multi-functional, antimicrobial composite. Materials 2020, 13, 3971. [Google Scholar] [CrossRef] [PubMed]
- Kudzin, M.H.; Kaczmarek, A.; Mrozińska, Z.; Olczyk, J. Deposition of copper on polyester knitwear fibers by a magnetron sputtering system. Physical properties, and evaluation of antimicrobial response of new multi-functional composite materials. Appl. Sci. 2020, 10, 6990. [Google Scholar] [CrossRef]
- Kudzin, M.H.; Boguń, M.; Mrozińska, Z.; Kaczmarek, A. Physical properties, chemical analysis, and evaluation of antimicrobial response of new polylactide/alginate/copper composite materials. Mar. Drugs 2020, 18, 660. [Google Scholar] [CrossRef] [PubMed]
- Kudzin, M.H.; Mrozi´nska, Z.; Urbaniak, P. Vapor phosphorylation of cellulose by phosphorus TrichloRide: Selective phosphorylation of 6-hydroxyl function—The synthesis of new antimicrobial cellulose 6-phosphate(III)-copper complexes. Antibiotics 2021, 10, 203. [Google Scholar] [CrossRef] [PubMed]
- Stańczyk, B.; Dobrzański, L.; Góra, K.; Jach, K.; Jagoda, A. Hydrophobic organic layers on smooth and 3-dimensional developed surfaces. Electron. Mater. 2015, 43, 3. [Google Scholar]
- Analytical Methods for Atomic Absorption Spectroscopy. The Perkin-Elmer Corporation, 1996. Available online: www1.lasalle.edu/ (accessed on 3 July 2020).
- EN ISO 20645:2006. Textile Fabrics. Determination of Antibacterial Activity—Agar Diffusion Plate Test; International Organization for Standardization: Geneva, Switzerland, 2006. [Google Scholar]
- EN 14119: 2005 Point 10.5 (B2). Testing of Textiles. Evaluation of the Action of Microfungi. Visual Method; International Organization for Standardization: Geneva, Switzerland, 2005. [Google Scholar]

| Parameter | Value |
|---|---|
| Extruder screw zone temperatures | 195–260 °C |
| Extruder head temperature | 260 °C |
| Air temperature | 260 °C |
| Air flow rate | 8 m3/h |
| The area density of nonwoven fabric | 250 g/m2 |
| Sample Assignments/Name | Mixture Components of Film-Forming Material (%) | ||
|---|---|---|---|
| Sodium Alginate Solution | Zinc (II) Chloride Solutions | ||
| 0.5% | 5% | 10% | |
| PLA | − | − | − |
| PLA-Alg-Na(+) | + | − | − |
| PLA-Alg-Zn(2+)-1 | + | + | − |
| PLA-Alg-Zn(2+)-2 | + | − | + |
| PLA | |||||
| Atom | C | O | |||
| At. % | 54.70 | 45.30 | |||
| Std. dev. | 0.18 | 0.18 | |||
| Wt. % | 47.55 | 52.46 | |||
| Std. dev. | 0.18 | 0.18 | |||
| PLA-ALG-Na(+) | |||||
| Atom | C | O | Na | ||
| At. % | 54.42 | 43.93 | 1.65 | ||
| Std. dev. | 1.61 | 2.55 | 0.03 | ||
| Wt. % | 45.45 | 52.09 | 2.47 | ||
| Std. dev. | 0.54 | 0.13 | 0.29 | ||
| PLA-ALG-Zn(2+) | |||||
| Atom | C | O | Na | Zn | Cl |
| At. % | 31.31 | 34.05 | 3.42 | 14.22 | 17.01 |
| Std. dev. | 1.21 | 3.58 | 0.76 | 0.52 | 1.29 |
| Wt. % | 14.62 | 21.18 | 4.61 | 36.14 | 23.45 |
| Std. dev. | 2.08 | 2.38 | 0.88 | 1.52 | 4.13 |
| Sample Name | Specific Surface Area [m2/g] | Total Pore Volume [cm3/g] |
|---|---|---|
| PLA | 0.221 ± 0.03 | 9.10 × 10−4 |
| PLA-Alg-Na(+) | 0.587 ± 0.03 | 1.64 × 10−3 |
| PLA-Alg-Zn(2+)-1 | 0.521 ± 0.02 | 2.75 × 10−3 |
| PLA-Alg-Zn(2+)-2 | 0.833 ± 0.03 | 3.09 × 10−3 |
| Sample | Zn Concentration [g/kg] |
|---|---|
| PLA | 0.003 |
| PLA-Alg-Na(+) | 0.003 |
| PLA-Alg-Zn(2+)-1 | 11.55 |
| PLA-Alg-Zn(2+)-2 | 39.71 |
| Sample | Average Inhibition Zone (mm) | |
|---|---|---|
| E. coli | S. aureus | |
| PLA nonwoven | 0 | 0 |
| PLA-Alg-Na(+) | 0 | 0 |
| PLA-Alg-Zn(2+)-1 | 0 | >1 |
| PLA-Alg-Zn(2+)-2 | >1 | >1 |
| Concentration of inoculum [CFU/mL]: E. Coli—1.8 × 108, S. Aureus—1.6 × 108 | ||
| Sample | Average Inhibition Zone (mm) | Visual Evaluation | |
|---|---|---|---|
| A. niger | C. globosum | ||
| PLA nonwoven | 0 | 0 | Visible, strong growth on/under the sample |
| PLA-Alg-Na(+) | |||
| PLA-Alg-Zn(2+)-1 | <1 | <1 | No visible growth on/under the sample |
| PLA-Alg-Zn(2+)-2 | |||
| Concentration of inoculum [CFU/mL]: A. niger—2.8 × 106, C. globosum—2.2 × 106 | |||
Publisher’s Note: MDPI stays neutral with regard to jurisdictional claims in published maps and institutional affiliations. |
© 2021 by the authors. Licensee MDPI, Basel, Switzerland. This article is an open access article distributed under the terms and conditions of the Creative Commons Attribution (CC BY) license (https://creativecommons.org/licenses/by/4.0/).
Share and Cite
Kudzin, M.H.; Giełdowska, M.; Mrozińska, Z.; Boguń, M. Poly(lactic acid)/Zinc/Alginate Complex Material: Preparation and Antimicrobial Properties. Antibiotics 2021, 10, 1327. https://doi.org/10.3390/antibiotics10111327
Kudzin MH, Giełdowska M, Mrozińska Z, Boguń M. Poly(lactic acid)/Zinc/Alginate Complex Material: Preparation and Antimicrobial Properties. Antibiotics. 2021; 10(11):1327. https://doi.org/10.3390/antibiotics10111327
Chicago/Turabian StyleKudzin, Marcin H., Małgorzata Giełdowska, Zdzisława Mrozińska, and Maciej Boguń. 2021. "Poly(lactic acid)/Zinc/Alginate Complex Material: Preparation and Antimicrobial Properties" Antibiotics 10, no. 11: 1327. https://doi.org/10.3390/antibiotics10111327
APA StyleKudzin, M. H., Giełdowska, M., Mrozińska, Z., & Boguń, M. (2021). Poly(lactic acid)/Zinc/Alginate Complex Material: Preparation and Antimicrobial Properties. Antibiotics, 10(11), 1327. https://doi.org/10.3390/antibiotics10111327

